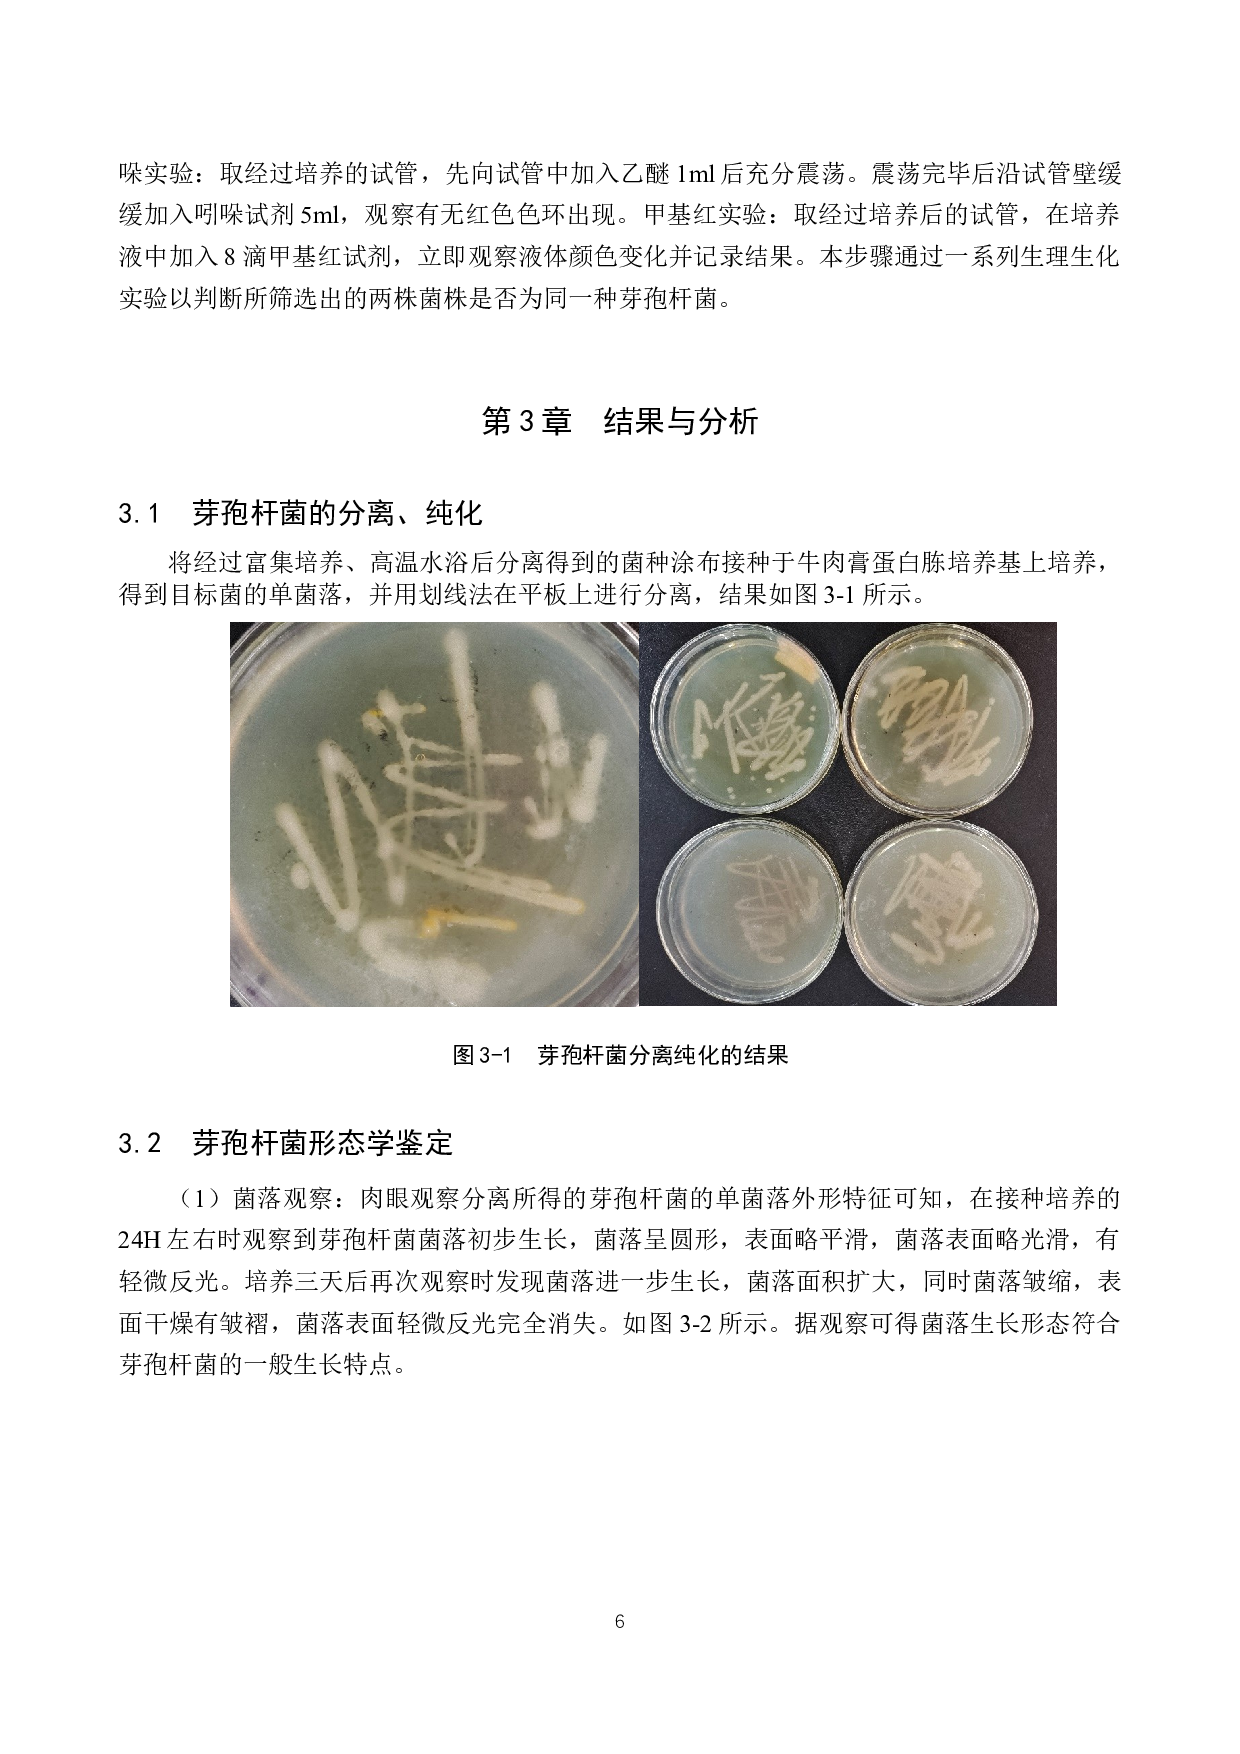
产淀粉酶芽孢杆菌的分离筛选-8533字.docx 第9页
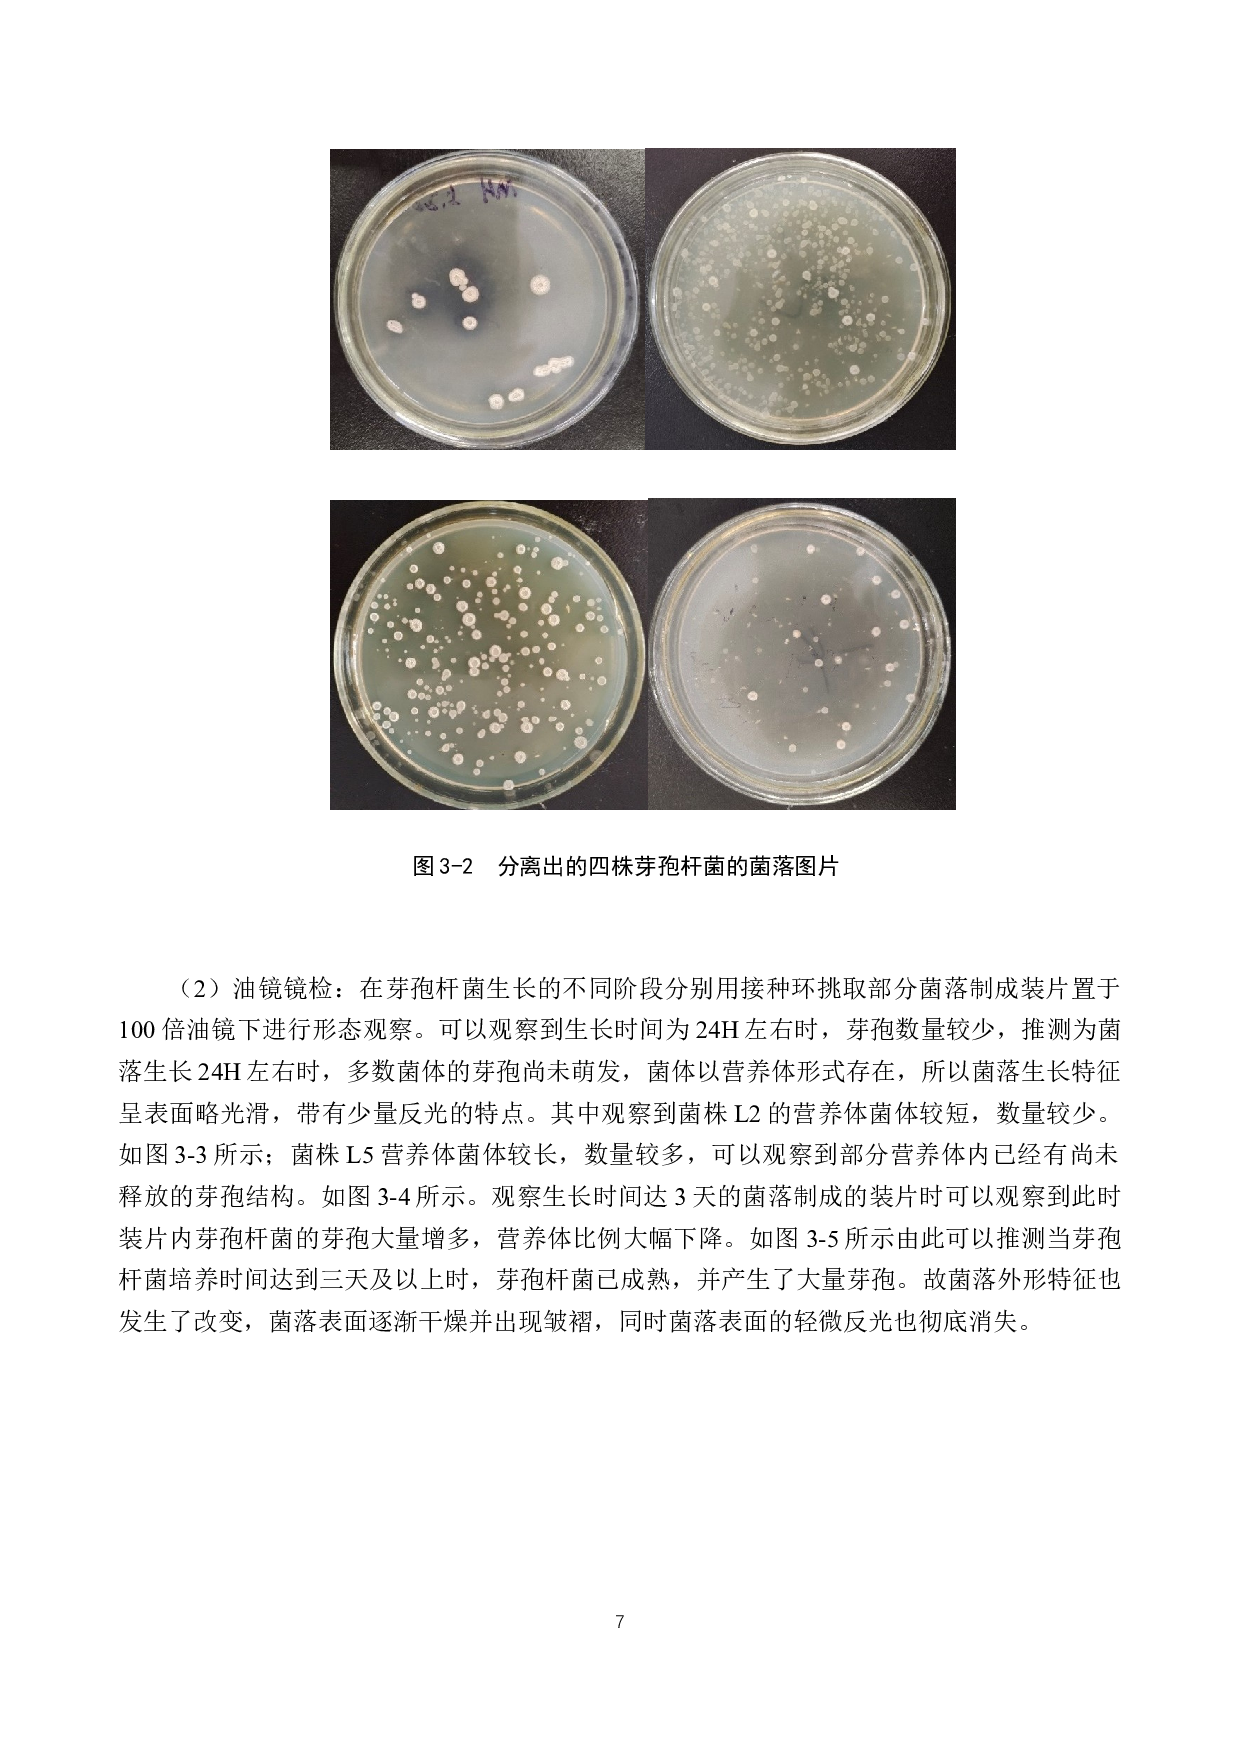
产淀粉酶芽孢杆菌的分离筛选-8533字.docx 第10页

摘
要
本实验旨
在从土壤中筛选具有产淀粉酶活性的芽孢杆菌
。结合
筛选出的
五株
耐高温
菌株的形态特征和镜检结果
后确定
其中的两株为芽孢杆菌
菌株分别为
:菌株L
2
和菌株L
5
。然后对这两株
分离出的
芽孢杆菌进行富集培养与梯度稀释分离
后进行一系列产淀粉酶活性测定实验。
将筛选出的两株芽孢杆菌
分别
接种在淀粉培养基上进行培养实验。经过培养和观察后,
确定筛选出的两株菌株都具备分解淀粉的活性,其中
菌株L
2
的
菌落直径平均值为1
0.1
mm,
淀粉水解
圈
直径平均值
为
15.2
mm
:
菌株L
5
的
菌落直径平均值为2
.3
mm
产淀粉酶芽孢杆菌的分离筛选-8533字.docx